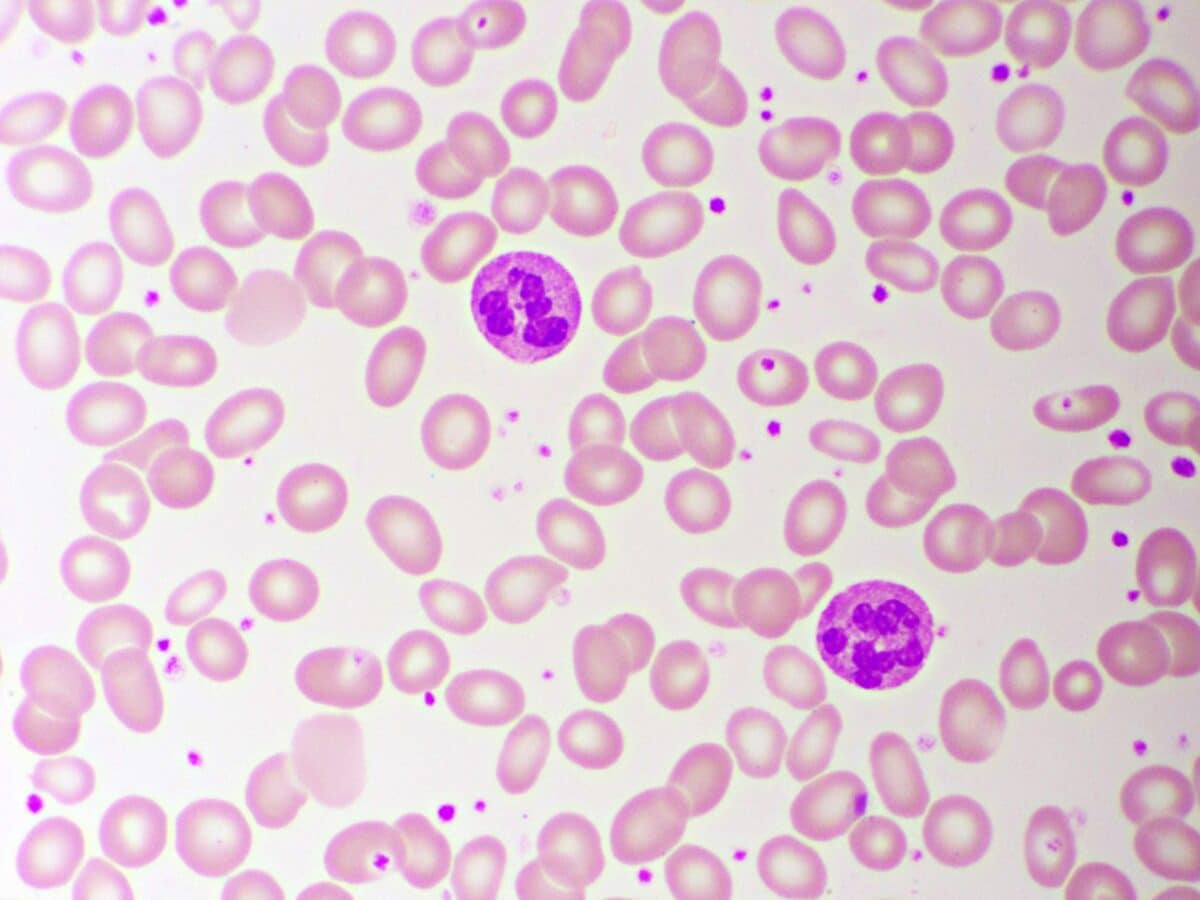
Segmented neutrophil cell in human blood smear

(Photo by siamionau pavel on Shutterstock)
In a nutshell
- High-fat diets significantly impair neutrophils—your immune system’s first responders—making them less effective at capturing and killing bacteria
- These effects begin after just one week on a high-fat diet, suggesting even short-term poor dietary choices can compromise immune function
- The research helps explain why people with obesity often experience more severe bacterial infections and have longer recovery times
ANN ARBOR, Mich. — A burger here, some fries there—we know these foods expand our waistlines, but researchers have uncovered something far more troubling about high-fat diets. According to new findings from University of Michigan scientists, eating too much fat could seriously hobble your immune system’s first line of defense against invaders.
The research, published in The Journal of Immunology, reveals that a high-fat diet wrecks the function of neutrophils—white blood cells that rush to infection sites to gobble up and destroy bacteria. These compromised cells become sluggish and ineffective, explaining why people carrying extra weight often get sicker from bacterial infections.
Scientists have long noticed that individuals with obesity face worse outcomes from infections, but the biological mechanisms behind this phenomenon remained fuzzy. This study rips away that uncertainty, showing exactly how dietary fat messes with our immune defenses at the cellular level.
The Battlefield: Fat vs. Immune Cells
The Michigan team examined male mice fed either normal chow or a diet where 60% of calories came from fat for periods ranging from a week to four months. After isolating neutrophils from bone marrow and blood, they subjected these cells to various tests against common bacteria.
Neutrophils from the high-fat diet mice performed dismally. When facing Pseudomonas aeruginosa, a bacterium that can cause severe infections, these cells caught and killed significantly fewer bacteria compared to neutrophils from mice on regular diets.
Surprisingly, these immune cells weren’t more inflammatory as expected. In fact, neutrophils from high-fat diet mice actually released less tumor necrosis factor alpha (TNFα), an inflammatory signaling molecule, under normal conditions.
Digging deeper with advanced genetic analysis, researchers found that neutrophils from fat-fed mice ramped up genes involved in fat metabolism and storage. The cells altered their energy processing methods—rather than primarily burning glucose for fuel, they shifted toward handling more fat. This metabolic adaptation came with serious consequences for their bacteria-fighting abilities.
Fat’s Fast and Devastating Impact
The damage extends beyond infection fighting. High-fat diet exposure impaired neutrophils’ ability to promote blood vessel regeneration. In bone marrow transplantation tests, neutrophils from normal-diet mice significantly enhanced blood vessel regrowth, while neutrophils from high-fat diet mice barely helped.
Most alarming, these effects started quickly. After just one week of high-fat feeding, researchers saw significant expansion of the neutrophil pool in bone marrow, indicating dietary changes impact our immune system almost immediately.
To confirm fat itself directly causes these problems, researchers exposed normal neutrophils to palmitate, a saturated fatty acid common in high-fat diets. Even brief exposure to this fat compromised their ability to engulf and kill bacteria, proving a direct link between dietary fat and immune dysfunction.
Neutrophils from fat-fed mice also formed fewer neutrophil extracellular traps (NETs)—web-like structures of DNA and proteins that trap and kill pathogens. This reduction happened both when exposed to bacteria and to chemical stimulants, representing yet another way high-fat diets compromise immune function.
Why It Matters for Your Health
With obesity rates climbing worldwide, understanding how diet affects immune function becomes increasingly important. This research opens potential pathways for treatments that could restore neutrophil function in people with obesity.
For average people, this research drives home how diet affects health beyond weight and heart disease. What you eat directly impacts your body’s defense system against bacterial invaders.
The twin challenges of rising obesity rates and infectious disease threats are not to be taken lightly. It’s why these connections between diet, metabolism, and immune function take on greater significance. This study illuminates one piece of that puzzle, showing how dietary choices directly weaken our immune defenses.
“We hope to build on these findings by uncovering what is causing the impairment of neutrophils exposed to high-fat diet,” says lead researcher Dr. Kanakadurga Singer, an associate professor at the University of Michigan Medical School, in a statement. “My team plans to conduct further studies on why these neutrophils are defective, especially in their bacterial killing function, and if these neutrophils are impaired in killing specific types of bacteria or a wide range. Hopefully, we can identify other implications of neutrophil dysfunction due to high-fat diet and if there are ways to improve this impaired function.”
So next time you’re considering that extra helping of high-fat food, remember your immune system might pay the price—leaving you more vulnerable when bacteria attack.
Paper Summary
Methodology
The researchers used male C57Bl/6J mice (a common lab mouse strain), feeding them either regular chow or a high-fat diet (60% calories from fat) for periods from 1 to 16 weeks. After these feeding periods, they isolated neutrophils from both bone marrow and blood using special separation techniques. They tested these neutrophils against Pseudomonas aeruginosa bacteria to measure their ability to engulf and destroy pathogens. They also examined whether the neutrophils could form those web-like neutrophil extracellular traps (NETs) that normally capture bacteria. To see what was happening at the genetic level, they used single-cell RNA sequencing to analyze gene expression in individual cells. They measured metabolic activity using Seahorse analysis, which checks how cells produce energy. In some experiments, they directly exposed normal neutrophils to palmitate (a fatty acid) to see if fat exposure alone caused similar problems. They also used a bone marrow transplantation model to test if the neutrophils could still promote blood vessel regeneration, another key function of these cells.
Results
The mice on high-fat diets had many more neutrophils in their bone marrow than mice on normal diets, but these cells performed poorly. Neutrophils from high-fat diet mice showed roughly 30-40% worse ability to engulf bacteria and a similar decrease in killing bacteria they had consumed. They also formed fewer NETs when exposed to bacteria or chemical stimulants. The neutrophils from high-fat diet mice contained more fat droplets and showed changes in genes related to fat processing, suggesting alterations in their energy metabolism. The high-fat diet also shifted the balance of neutrophil types, increasing both immature and aged neutrophils without changing mature neutrophil numbers. When they directly exposed normal neutrophils to palmitate, these cells showed similar defects in bacterial capture and killing, confirming that fat exposure alone harms neutrophil function. In the bone marrow transplant model, neutrophils from high-fat diet mice were much worse at promoting blood vessel regrowth compared to cells from mice on normal diets.
Limitations
This study has important limitations to keep in mind. Since it used only male mice, we don’t know if females would respond the same way to high-fat diets. Previous research shows sex differences in obesity-related inflammation, so this matters. The researchers used an extreme diet (60% calories from fat), far higher than typical human high-fat diets. We don’t know if more moderate fat increases would cause similar problems. The study doesn’t explore whether these changes reverse if mice return to normal diets after fat feeding. While they identified changes in fat metabolism genes in neutrophils from high-fat diet mice, they didn’t directly manipulate these genes to confirm their role in the problems observed. The research doesn’t address whether different types of fats (saturated vs. unsaturated) might affect neutrophils differently. Finally, while the study shows impaired neutrophil function, it doesn’t directly demonstrate whether these changes actually increase infection susceptibility in living organisms, which would require additional experiments.
Discussion and Takeaways
This research helps explain why people with obesity might catch more infections. By showing that high-fat diets impair multiple neutrophil functions—including bacterial capture, killing, and NET formation—it suggests compromised immunity results directly from dietary choices. Interestingly, it challenges the common belief that obesity mainly increases inflammation. Instead, neutrophils from high-fat diet mice actually released less TNFα at baseline, suggesting a more complex relationship between diet and immune responses. The observed changes in neutrophil metabolism—particularly increased fat storage and altered expression of fat-processing genes—highlight how diet fundamentally changes cellular function. This points to potential treatments that might normalize fat metabolism in immune cells for people with obesity. The research also emphasizes neutrophil diversity, showing high-fat diets alter the balance of neutrophil subpopulations. Overall, the findings suggest dietary changes might improve immune function in people with obesity, potentially reducing infection risks.
Funding and Disclosures
This research received support from multiple sources, including the American Heart Association (AHA 20POST35120473), the National Institute of Diabetes and Digestive and Kidney Diseases (NIH/NIDDK R01DK11583 and K26DK138307), and the Department of Pediatrics Valerie Castle Opipari M.D. Professorship at the University of Michigan. Additional funding came from the University of Michigan Pandemic Research Recovery Grant, NIH/NHLBI R35HL144481, and NIH/NIDDK DK124290. The researchers declared no conflicts of interest.
Publication Details
The study “High fat diet feeding impairs neutrophil phagocytosis, bacterial killing, and neutrophil-induced hematopoietic regeneration” appeared in The Journal of Immunology in March 2025. Emily Bowers, Gabrielle P. Entrup, Mohammed Islam, Ramkumar Mohan, Arianna Lerner, Peter Mancuso, Bethany B. Moore, and Kanakadurga Singer conducted the research across various University of Michigan Medical School departments, including Pediatrics, Immunology, Nutritional Sciences, Microbiology and Immunology, and Molecular and Integrative Physiology.







